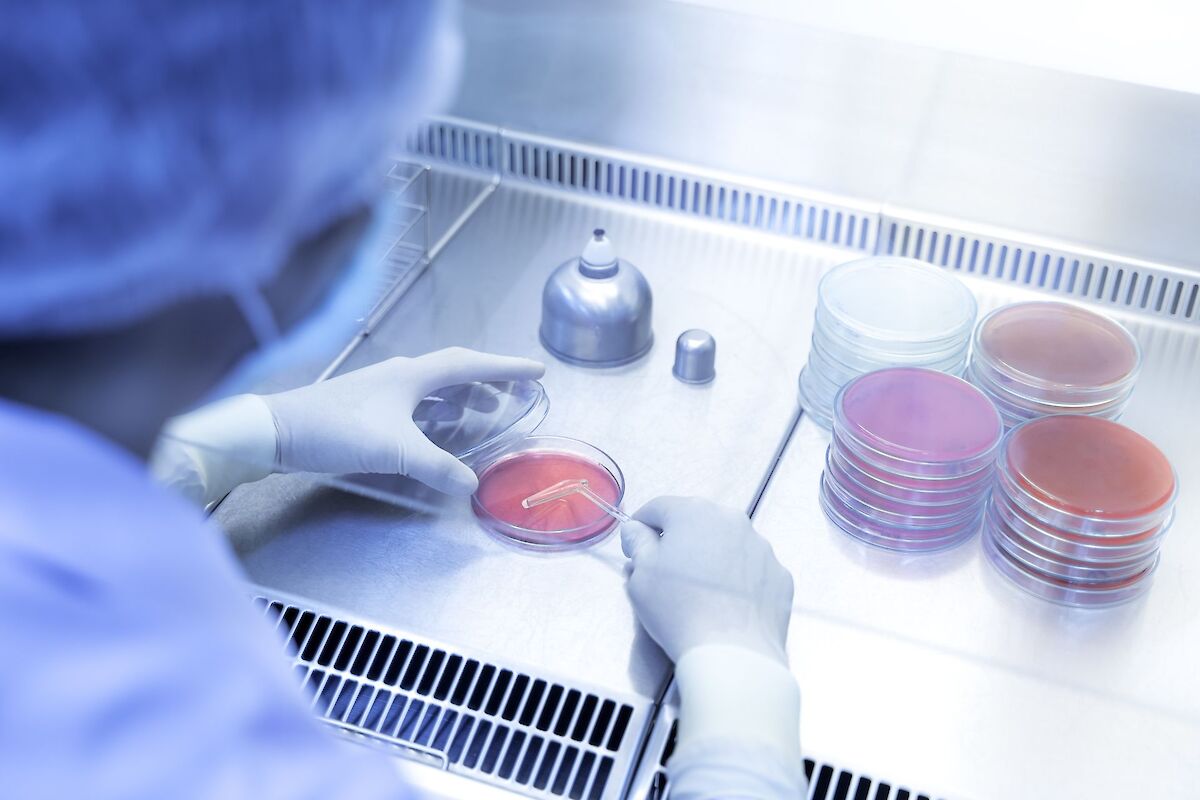

Testauskapasiteettia nostetaan, tehohoitopaikat tuplataan
STM kertoi uusista toimistaan perjantaina iltapäivällä tiedotustilaisuudessa.
Sosiaali- ja terveysministeriö linjasi tänään, että välttämättömät sosiaali- ja terveydenhuollon palvelut on taattava myös poikkeusoloissa. STM:n mukaan sosiaali- ja terveydenhuoltolaki on edelleen voimassa ja sitä on noudatettava.
Perhe- ja peruspalveluministeri Krista Kiuru lähetti tiukan viestin kentälle, että perusterveydenhuoltoa ei voida ajaa kunnissa etukenossa alas.
– Toiminta on pyrittävä järjestämään kunnassa tarvetta vastaavalla tavalla, hän sanoi.
Perustason toimintoja ei tule vähentää tarpeettomasti, vaan normaalitaso pitää säilyttää mahdollisimman pitkään. Ennaltaehkäisevää hoitoa on pystyttävä järjestämään ja pyrittävä huomioimaan haavoittuvassa asemassa olevat ihmiset ensisijaisesti. Mitä paremmin perusterveydenhuolto toimii, sitä vähemmän se rasittaa erikoissairaanhoitoa.
– Osastotoimintoja voidaan harkitusti supistaa, kun infektiotilanne alkaa olla sellainen. Tosiasia on, että perusterveydenhuollon toimivuus täytyy olla kunnossa, Kiuru muistutti.
STM:n mukaan kuntien on tiedotettava yli 70-vuotiaita, että mistä apua on saatavissa.
Kotihoidossa ja ympärivuorokautisessa hoidossa on noudatettava valtioneuvoston vierailijakieltoa koko maassa. Vierailukielto ei koske tapauskohtaisesti arvioiden kriittisesti sairaiden ja lasten oireettomia läheisiä, saattohoidossa olevien läheisiä sekä puolisoa tai tukihenkilöä synnytysosastolla. Kaikki päivätoimintaryhmät on syytä peruuttaa.
Kotihoidon työntekijöiden on huolehdittava, että ovat suojautuneet esimerkiksi hengityssuojaimin. Kotihoidossa on pyrittävä, että samat työntekijät hoitavat samoja potilaita. Näin tartuntariski voidaan minimoida.
Tehohoitokapasiteettia nostetaan
Suomessa on tällä hetkellä noin 300 tehohoitopaikka ja noin 150–200 tehovalvontapaikkaa. Kapasiteetti voidaan tuplata muuttamalla valvontapaikkoja, leikkaussaleja ja heräämöjen hoitopaikkoja. Samalla kiireetöntä leikkaustoimintaa supistetaan, koska tehovalvontaa tai jopa tehohoitoa tarvitsevat myös muut kuin koronapotilaat.
– Sydänpotilaat ja muut kiireelliset sairaudet hoidetaan. Ketään heistä ei jätetä leikkaamatta, muistuttaa Kiuru.
Kiuru jatkaa, että leikkaustoiminnassa on alueellista vaihtelua, joten tarvitaan erilaisia toimia, riippuen kuinka nopeasti epidemia etenee.
Sairaanhoitopiirit ovat vähentäneet kiireetöntä kapasiteettia arviolta 10–25 prosenttia, mutta siinä on alueellista vaihtelua. Ensi viikon aikana STM arvioi, että kolmasosa kapasiteetista on siirretty kiireelliseen hoitoon varustautumiseen. Samalla järjestetään lisäperehdytystä, jotta valvontaosastojen, heräämöjen ja leikkaussalien anestesiasairaanhoitajilla on pätevyys toimia tehohoitotyössä.
Testejä yhä useammalle
THL:n tilastojen mukaan Suomessa on testattu perjantaihin mennessä 6 500 henkilöä koronaviruksen varalta. Varmistettuja tartuntoja on 450 henkilöllä. Tehohoidossa on Suomessa tällä hetkellä viisi potilasta ja 17 hoidetaan osastohoidossa. Raportoiduista tapauksista 61 prosenttia on miehiä ja 39 prosenttia naisia.
Samaan hengenvetoon Kiuru kertoi, että testauskapasiteettia on nostettu nyt 1 500 näytteeseen päivässä. Jatkossa määrää aiotaan kasvattaa 2 300 näytteeseen päivässä. Jatkossa testejä aiotaan tehdä matalammalla kynnyksellä, mutta noudattaen THL:n ohjeita.
Kiuru kertoi tiedotustilaisuudessa myös, että Lapin hiihtokeskuksista on todettu kaksi koronavirustartuntaketjua.
– Moite niille, jotka eivät ole ottaneet tätä asiaa vakavasti, Kiuru totesi.
Moni hiihtokeskus onkin ilmoittanut nyt, että sulkevat ovensa viimeistään ensi viikolla.
– Tarvittaessa voidaan ottaa keinoja, joita valmiuslaki ei sisällä. Liikkumisrajoitukset ovat keinovalikoimassa, jos sellainen vaaditaan.